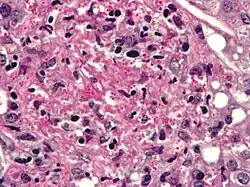

Fungo patogênico
Fungos patogênicos são fungos que causam doenças em humanos ou outros organismos. Embora os fungos sejam eucariontes, muitos fungos patogênicos são microrganismos.[1] Aproximadamente 300 fungos são conhecidos por serem patogênicos para humanos;[2] seu estudo é chamado de micologia médica. Estima-se que infecções fúngicas matem mais pessoas do que tuberculose ou malária — cerca de dois milhões de pessoas por ano.[3]
Em 2022, a Organização Mundial da Saúde (OMS) publicou uma lista de patógenos fúngicos que devem ser prioritários para ações de saúde pública.[4]
Muitos mais fungos são conhecidos por serem patogênicos para plantas do que para animais.[5] O estudo de fungos e outros organismos patogênicos para plantas é chamado de fitopatologia.
Patógenos de especial preocupação
De acordo com a Organização Mundial da Saúde (OMS) em 2022, os patógenos de especial preocupação são:[4]
- Prioridade crítica
- Cryptococcus neoformans, Candida auris, Aspergillus fumigatus, Candida albicans.
- Prioridade alta
- Nakaseomyces glabrata (Candida glabrata), Histoplasma spp., agentes causadores de eumicetoma, Mucorales, Fusarium spp., Candida tropicalis, Candida parapsilosis.
- Prioridade média
- Scedosporium spp., Lomentospora prolificans, Coccidioides spp., Pichia kudriavzeveii (Candida krusei), Cryptococcus gattii, Talaromyces marneffei, Pneumocystis jirovecii, Paracoccidioides spp.
Candida

As espécies do gênero Candida causam infecções em indivíduos com sistemas imunológicos deficientes. Espécies de Candida são responsáveis pela maioria das infecções fúngicas, podendo causar infecções sistêmicas e superficiais.[6] A imunidade mediada por células Th1 é essencial para combater infecções fúngicas.
Candida albicans é uma levedura diploide comum na microbiota intestinal humana. É um patógeno oportunista em humanos, e seu crescimento excessivo pode ocorrer, especialmente em indivíduos imunocomprometidos.[7] C. albicans possui um ciclo parassexual que parece ser estimulado por estresse ambiental.[8]
C. auris, descrita pela primeira vez em 2009, é resistente a muitos antifúngicos, desinfetantes e calor, o que a torna extremamente difícil de erradicar. Como outros fungos patogênicos, afeta principalmente pessoas imunocomprometidas; quando atinge o sangue ou outros órgãos e tecidos, a mortalidade é de cerca de 50%.[3]
Outras espécies de Candida também podem ser patogênicas, incluindo Candida stellatoidea, C. tropicalis, C. pseudotropicalis, C. krusei, C. parapsilosis e C. guilliermondii [en].[9]
Aspergillus

As espécies patogênicas mais comuns são Aspergillus fumigatus e Aspergillus flavus. Aspergillus flavus produz aflatoxina, que é tanto uma toxina quanto um carcinógeno e pode contaminar alimentos como nozes. Aspergillus fumigatus e Aspergillus clavatus [en] podem causar doenças alérgicas. Algumas espécies de Aspergillus afetam culturas de grãos, especialmente milho, e sintetizam micotoxinas, incluindo aflatoxina. Aspergilose é o grupo de doenças causadas por Aspergillus, com sintomas como febre, tosse, dor torácica ou dificuldade respiratória. Geralmente, apenas pacientes com sistemas imunológicos enfraquecidos ou com outras condições pulmonares são suscetíveis.[1]
Os esporos de Aspergillus fumigatus são ubíquos na atmosfera. A. fumigatus é um patógeno oportunista que pode causar infecções invasivas potencialmente letais em indivíduos imunocomprometidos.[10]
Cryptococcus

Cryptococcus neoformans pode causar uma forma grave de meningite e meningoencefalite em pacientes com infecção por HIV e AIDS. A maioria das espécies de Cryptococcus vive no solo e não causa doenças em humanos. Cryptococcus neoformans é o principal patógeno humano e animal. Papiliotrema laurentii e Naganishia albida [en], anteriormente classificadas como Cryptococcus, podem ocasionalmente causar doenças moderadas a graves em pacientes humanos com imunidade comprometida. Cryptococcus gattii é endêmico em regiões tropicais da África e Austrália e pode causar doenças em pessoas não imunocomprometidas.[1]
As células infectantes de C. neoformans são geralmente fagocitadas por macrófagos alveolares [en] no pulmão.[11] Essas células podem ser destruídas pela liberação de moléculas oxidativas e nitrosativas pelos macrófagos.[12] No entanto, algumas células de C. neoformans podem sobreviver dentro dos macrófagos.[11] A capacidade do patógeno de sobreviver no ambiente intracelular hostil dos macrófagos provavelmente determina a latência da doença, sua disseminação e resistência a agentes antifúngicos. Para sobreviver nesse ambiente, C. neoformans aumenta a regulação positiva de genes envolvidos em respostas ao estresse oxidativo.[11]
Os núcleos haploides de C. neoformans podem sofrer fusão nuclear (cariogamia) para se tornarem diploides. Esses núcleos diploides podem então passar por meiose, incluindo recombinação genética, resultando na formação de basidiósporos haploides capazes de se dispersar.[13] A meiose pode facilitar o reparo de DNA em C. neoformans em resposta ao desafio dos macrófagos.[13][14]
Histoplasma
Histoplasma capsulatum pode causar histoplasmose em humanos, cães e gatos. O fungo é mais prevalente nas Américas, Índia e sudeste da Ásia. É endêmico em certas áreas dos Estados Unidos. A infecção geralmente ocorre pela inalação de ar contaminado.
Pneumocystis
Pneumocystis jirovecii (ou Pneumocystis carinii) pode causar uma forma de pneumonia em pessoas com sistemas imunológicos enfraquecidos, como crianças prematuras, pacientes em tratamento imunossupressor, idosos e pacientes com AIDS.[15]
Stachybotrys
Stachybotrys chartarum [en] pode causar danos respiratórios e dores de cabeça severas. É comum em casas e regiões cronicamente úmidas.[16]
Mecanismos de defesa do hospedeiro
Endotermia
A endotermia e a homeotermia dos mamíferos são defesas inespecíficas potentes contra a maioria dos fungos.[17] Um estudo genômico comparativo revelou que, em fungos oportunistas, há poucos ou nenhum traço de virulência especializado consistentemente ligado à patogenicidade oportunista em humanos, exceto a capacidade de crescer a 37 °C.[18]
Tecidos de barreira
A pele, o trato respiratório, o trato gastrointestinal e o sistema geniturinário são regiões comuns de infecção fúngica, frequentemente associadas a inflamações.
Resposta imune
Estudos demonstraram que hospedeiros com níveis mais altos de células da imunidade celular, como monócitos/macrófagos, células dendríticas e linfócitos NKT, apresentam maior controle do crescimento fúngico e proteção contra infecções sistêmicas. Receptor de reconhecimento de padrões (sigla em inglês: PRRs) desempenham um papel crucial na indução da resposta imune, reconhecendo patógenos fúngicos específicos e iniciando uma reação imune. No caso da candidíase mucosal, as células que produzem citocina IL-17 são extremamente importantes para manter a imunidade inata.[19]
Relação com a extremotolerância
Uma comparação abrangente da distribuição de patógenos oportunistas e fungos tolerantes a estresse na árvore da vida fúngica mostrou que a poliextremotolerância e a patogenicidade oportunista aparecem consistentemente nas mesmas ordens fúngicas, e que a coocorrência de oportunismo e extremotolerância (como osmotolerância e psicrotolerância) é estatisticamente significativa. Isso sugere que algumas adaptações a ambientes estressantes também podem promover a sobrevivência fúngica durante a infecção.[18]
Ver também
Referências
- ↑ a b c San-Blas G; Calderone RA, eds. (2008). Pathogenic Fungi: Insights in Molecular Biology. [S.l.]: Caister Academic Press. ISBN 978-1-904455-32-5
- ↑ «Stop neglecting fungi». Nature Microbiology. 2 (8). 17120 páginas. 25 de julho de 2017. PMID 28741610. doi:10.1038/nmicrobiol.2017.120
- ↑ a b Geddes, Linda (10 de fevereiro de 2023). «'A growing threat to human health': we are ill-equipped for the dangers of fungal infections». The Guardian
- ↑ a b WHO fungal priority pathogens list to guide research, development and public health action. [S.l.]: World Health Organization. 2022. ISBN 978-92-4-006025-8
- ↑ English, Mary P. (1980). Medical Mycology. London: Edward Arnold Publishers Limited. p. 5. ISBN 0-7131-2795-3
- ↑ Turner, S. A.; Butler, G. (1 de setembro de 2014). «The Candida Pathogenic Species Complex». Cold Spring Harbor Perspectives in Medicine (em inglês). 4 (9): a019778. ISSN 2157-1422. PMC 4143104
. PMID 25183855. doi:10.1101/cshperspect.a019778
- ↑ Martins N, Ferreira IC, Barros L, Silva S, Henriques M (2014). «Candidiasis: predisposing factors, prevention, diagnosis and alternative treatment». Mycopathologia. 177 (5–6): 223–40. PMID 24789109. doi:10.1007/s11046-014-9749-1. hdl:1822/31482
- ↑ Bennett RJ (2015). «The parasexual lifestyle of Candida albicans». Curr. Opin. Microbiol. 28: 10–7. PMC 4688137
. PMID 26210747. doi:10.1016/j.mib.2015.06.017
- ↑ Beneke, E. S. (1966). Medical Mycology: Laboratory Manual 2nd ed. Minneapolis, MN: Burgess Publishing Company. 161 páginas
- ↑ O'Gorman CM, Fuller H, Dyer PS (2009). «Discovery of a sexual cycle in the opportunistic fungal pathogen Aspergillus fumigatus». Nature. 457 (7228): 471–4. Bibcode:2009Natur.457..471O. PMID 19043401. doi:10.1038/nature07528
- ↑ a b c Fan W, Kraus PR, Boily MJ, Heitman J (2005). «Cryptococcus neoformans gene expression during murine macrophage infection». Eukaryotic Cell. 4 (8): 1420–33. PMC 1214536
. PMID 16087747. doi:10.1128/EC.4.8.1420-1433.2005
- ↑ Alspaugh JA, Granger DL (1991). «Inhibition of Cryptococcus neoformans replication by nitrogen oxides supports the role of these molecules as effectors of macrophage-mediated cytostasis». Infect. Immun. 59 (7): 2291–6. PMC 258009
. PMID 2050398. doi:10.1128/IAI.59.7.2291-2296.1991
- ↑ a b Lin X, Hull CM, Heitman J (2005). «Sexual reproduction between partners of the same mating type in Cryptococcus neoformans». Nature. 434 (7036): 1017–21. Bibcode:2005Natur.434.1017L. PMID 15846346. doi:10.1038/nature03448
- ↑ Bernstein H, Bernstein C, Michod RE (2018). «Sex in microbial pathogens». Infection, Genetics and Evolution. 57: 8–25. Bibcode:2018InfGE..57....8B. PMID 29111273. doi:10.1016/j.meegid.2017.10.024
- ↑ Ryan KJ; Ray CG, eds. (2004). Sherris Medical Microbiology 4th ed. [S.l.]: McGraw Hill. ISBN 978-0-8385-8529-0
- ↑ Bitnun, Ari; Nosal, Robert M (1999). «Stachybotrys chartarum (atra) contamination of the indoor environment: Health implications». Paediatrics & Child Health. 4 (2): 125–129. ISSN 1205-7088. PMC 2828207
. PMID 20212975. doi:10.1093/pch/4.2.125
- ↑ Robert, V. A.; Casadevall, A. (2009). «Vertebrate Endothermy Restricts Most Fungi as Potential Pathogens». The Journal of Infectious Diseases. 200 (10): 1623–1626. PMID 19827944. doi:10.1086/644642
- ↑ a b Gostinčar, Cene; Zajc, Janja; Lenassi, Metka; Plemenitaš, Ana; de Hoog, Sybren; Al-Hatmi, Abdullah M. S.; Gunde-Cimerman, Nina (1 de novembro de 2018). «Fungi between extremotolerance and opportunistic pathogenicity on humans». Fungal Diversity (em inglês). 93 (1): 195–213. ISSN 1878-9129. doi:10.1007/s13225-018-0414-8
. hdl:20.500.12556/DiRROS-19656
- ↑ Brown GD, Drummond RA, Gaffen SL, Hise AG (2015). «Innate Defense against Fungal Pathogens». Cold Spring Harb Perspect Med. 5 (6): a019620. PMC 4426252
. PMID 25384766. doi:10.1101/cshperspect.a019620
Leitura adicional
- Almeida F, Rodrigues ML, Coelho C (2019). «The Still Underestimated Problem of Fungal Diseases Worldwide». Front Microbiol. 10. 214 páginas. PMC 6379264
. PMID 30809213. doi:10.3389/fmicb.2019.00214